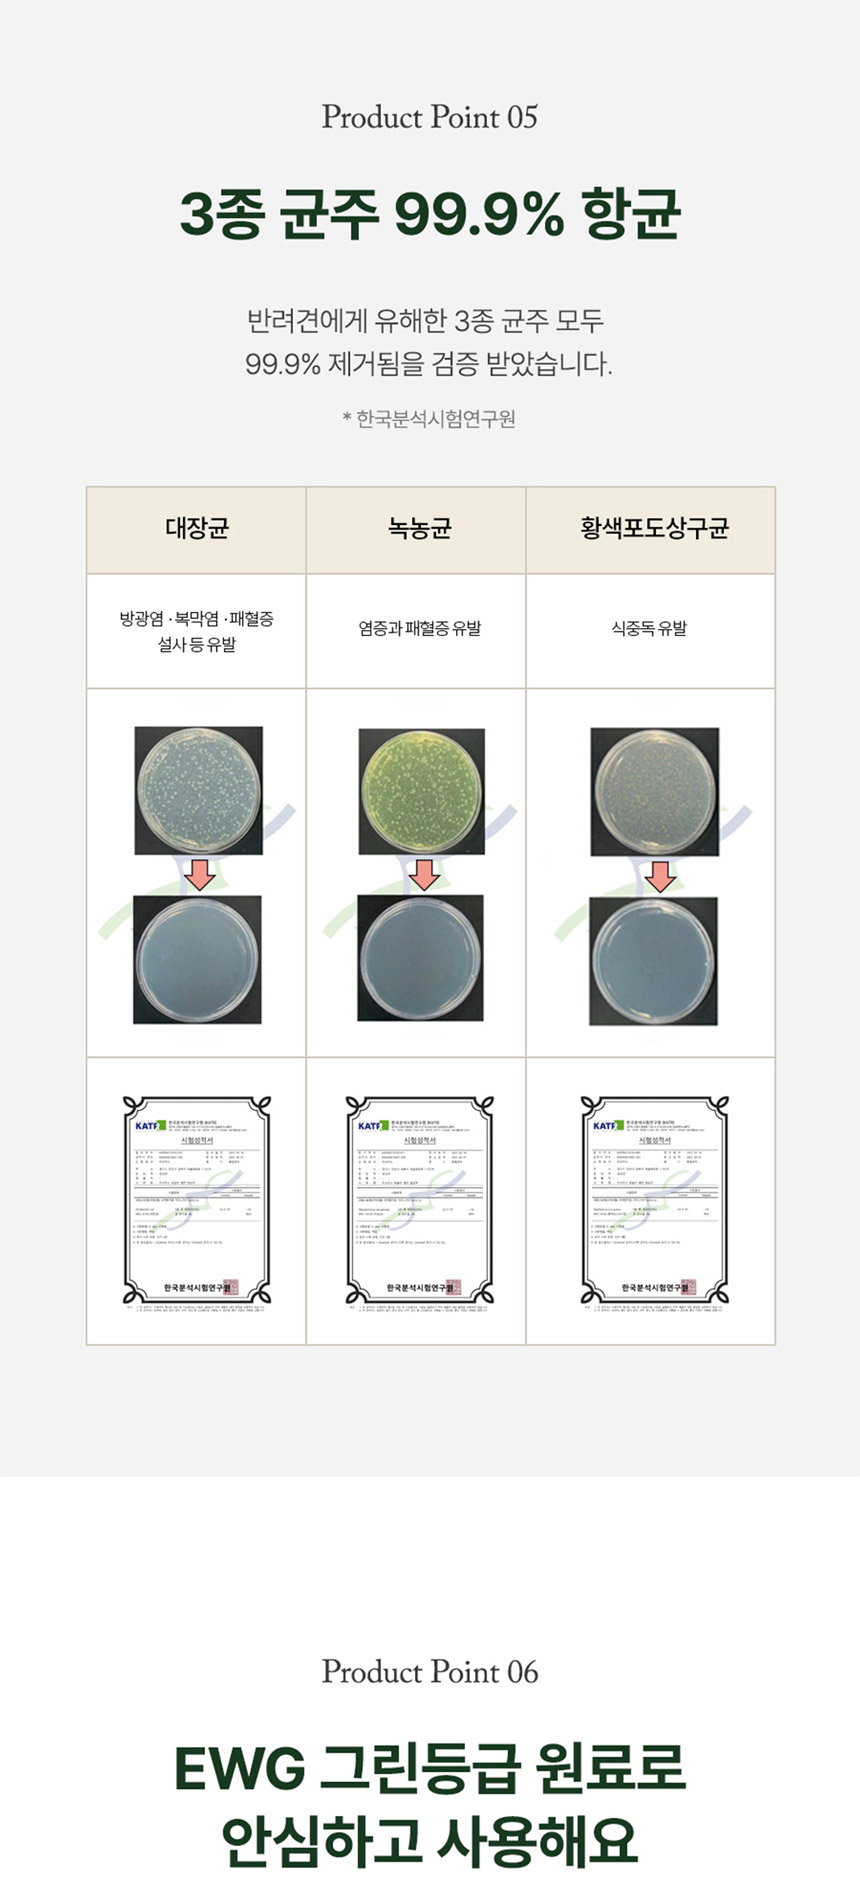

상품 필수 정보
브랜드 리꼬르소
제조사 -
배송비
1.기본 배송비는 3000원입니다.(도서 산간 오지 일부지역은 배송비가 추가될 수 있습니다.
2.주문금액 50000원 이상은 무료배송입니다.(단 중량초과인 경우 추가 요금이 부과될 수 있습니다.)
3.사료 주문시 업체 사정상 배송까지 1~10일 소요될 수 있습니다.
4. 제품 주문시 당일 오후 2시까지 입금 확인된 제품만 발송 준비됩니다.
교환/반품안내
1. 교환반품 가능 기간은 상품 수령일로부터 7일 이내입니다.
2. 상표제거 혹은 개봉으로 인한 상품가치 훼손, 패키지 손상시에는 7일이내라도 교환반품이 불가합니다(교환 반품시 동봉한 사은품도 반품해 주셔야 합니다).
3. 상품 반품시에는 왕복 택배비 7000원이 부과됩니다.(냉장배송,중량 5kg이상인 경우 기본 반품비외에 2000원 이상 추가 될 수 있습니다.)
4. 교환 반품시 청담우리몰의 계약사인 (대한통운택배)를 이용하지 않을시에는 계약요금 이외에 추가 요금을 부담하실 수 있습니다.
5. 반품 배송지 : 강남구 압구정로4길 11 실로암빌딩 2층
품질보증기준 품질보증기준 관련 법 및 소비자 분쟁 해결 기준에 따름

